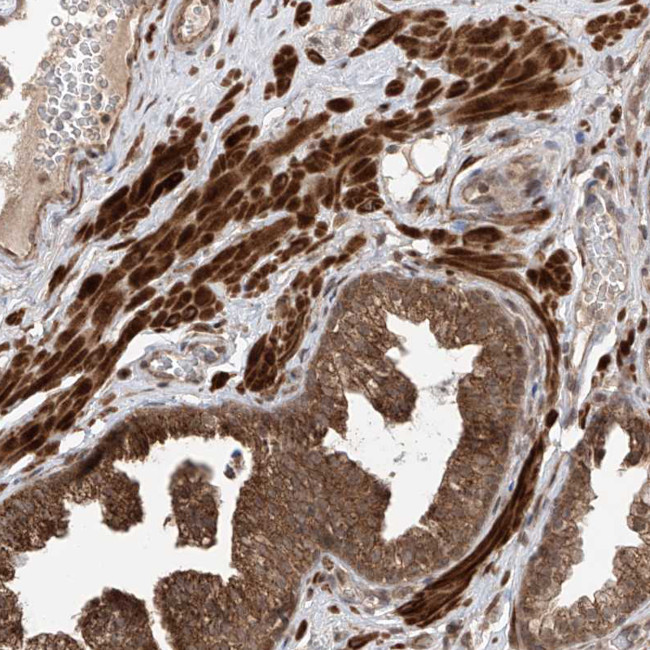
LATS1 Antibody in Immunohistochemistry (Paraffin) (IHC (P))
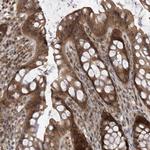
LATS1 Antibody in Immunohistochemistry (Paraffin) (IHC (P))

Search
Invitrogen
LATS1 Polyclonal Antibody
{{$productOrderCtrl.translations['antibody.pdp.commerceCard.promotion.promotions']}}
{{$productOrderCtrl.translations['antibody.pdp.commerceCard.promotion.viewpromo']}}
{{$productOrderCtrl.translations['antibody.pdp.commerceCard.promotion.promocode']}}: {{promo.promoCode}} {{promo.promoTitle}} {{promo.promoDescription}}. {{$productOrderCtrl.translations['antibody.pdp.commerceCard.promotion.learnmore']}}
产品信息
PA5-83209
种属反应
宿主/亚型
分类
类型
抗原
偶联物
形式
浓度
规格
纯化类型
保存液
内含物
保存条件
运输条件
RRID
产品详细信息
Immunogen sequence: PSWEPNSQTK RYSGNMEYVI SRISPVPPGA WQEGYPPPPL NTSPMNPPNQ GQRGISSVPV GRQPIIMQSS SKFNFPSGRP
Highest antigen sequence indentity to the following orthologs: Mouse - 90%, Rat - 96%.
靶标信息
LATS1 is a putative serine/threonine kinase that localizes to the mitotic apparatus and complexes with cell cycle controller CDC2 kinase in early mitosis which is phosphorylated in a cell-cycle dependent manner. The N-terminal region of the protein binds CDC2 to form a complex showing reduced H1 histone kinase activity which indicating a role as a negative regulator of CDC2/cyclin A and the C-terminal kinase domain binds to its own N-terminal region, suggesting potential negative regulation through interference with complex formation via intramolecular binding. LATS1 act as a tumor suppressor and play an important role in the development of soft-tissue sarcomas, ovarian stromal cell tumors and a high sensitivity to carcinogenic treatments.
仅用于科研。不用于诊断过程。未经明确授权不得转售。
篇参考文献 (0)
生物信息学
蛋白别名: h-warts; Large tumor suppressor homolog 1; LATS (large tumor suppressor, Drosophila) homolog 1; LATS, large tumor suppressor, homolog 1; putative serine threonine kinase; Serine/threonine-protein kinase LATS1; similar to Drosophila warts tumor suppressor; WARTS protein kinase
基因别名: LATS1; WARTS; wts
UniProt ID: (Human) O95835
Entrez Gene ID: (Human) 9113